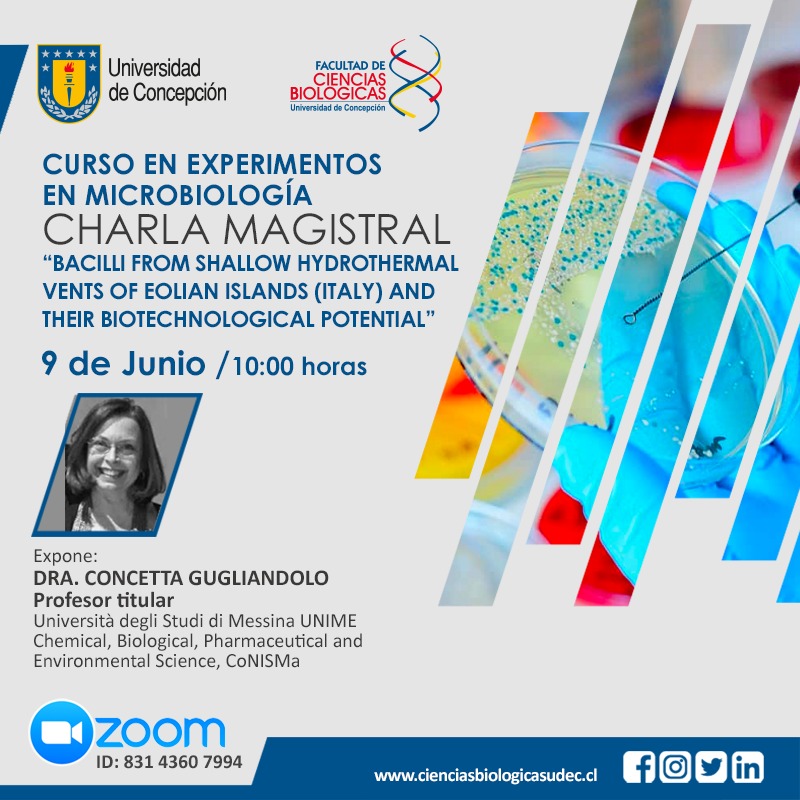

Atención
#comunidadFCB este 9 de junio a las 10h. tendremos el honor de ser partícipes de la Charla Magistral de la Dra. Concetta Gugliandolo, profesora titular de la
Università degli Studi di Messina en el contexto del Curso en experimentos en Microbiología

¡Nos vemos por zoom!